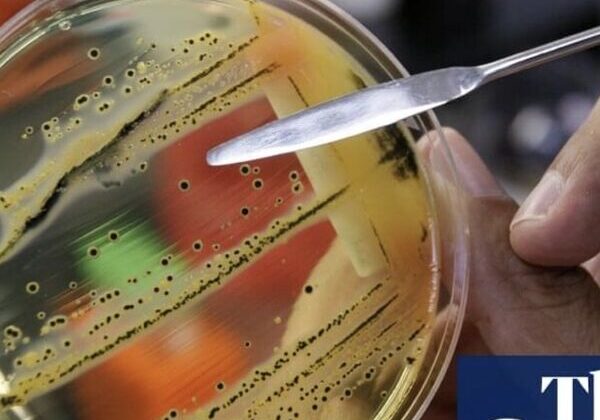
Petri dish with bacterial colonies and tool.

Insights from Supporting Food Manufacturers

35+ people sick in an E. coli outbreak
E. coli infections and outbreaks are common worldwide and pose significant health risks. While many strains of E. coli are...

The Spice Scandal
The recent safety scare prompted the Food Standards Authority of India (FSSAI) to cancel licenses for 111 spice producers within...

Contaminated Kimchi Epidemic
Korean school meals, typically regarded for their nutritional benefits, became the focal point of an outbreak, raising significant public health...

E.coli outbreak!
Such outbreaks have a profound impact on public health and public trust in food supply chains. This incident underscores the...

Lead in Applesauce – Gaps in Food Safety
This case highlights flaws in food safety systems that allow contaminated products to reach consumers without adequate testing, particularly in...

When is keeping pace not a good thing?
When is keeping pace not a good thing? When it is for Police and Criminal Evidence. This is happening more...